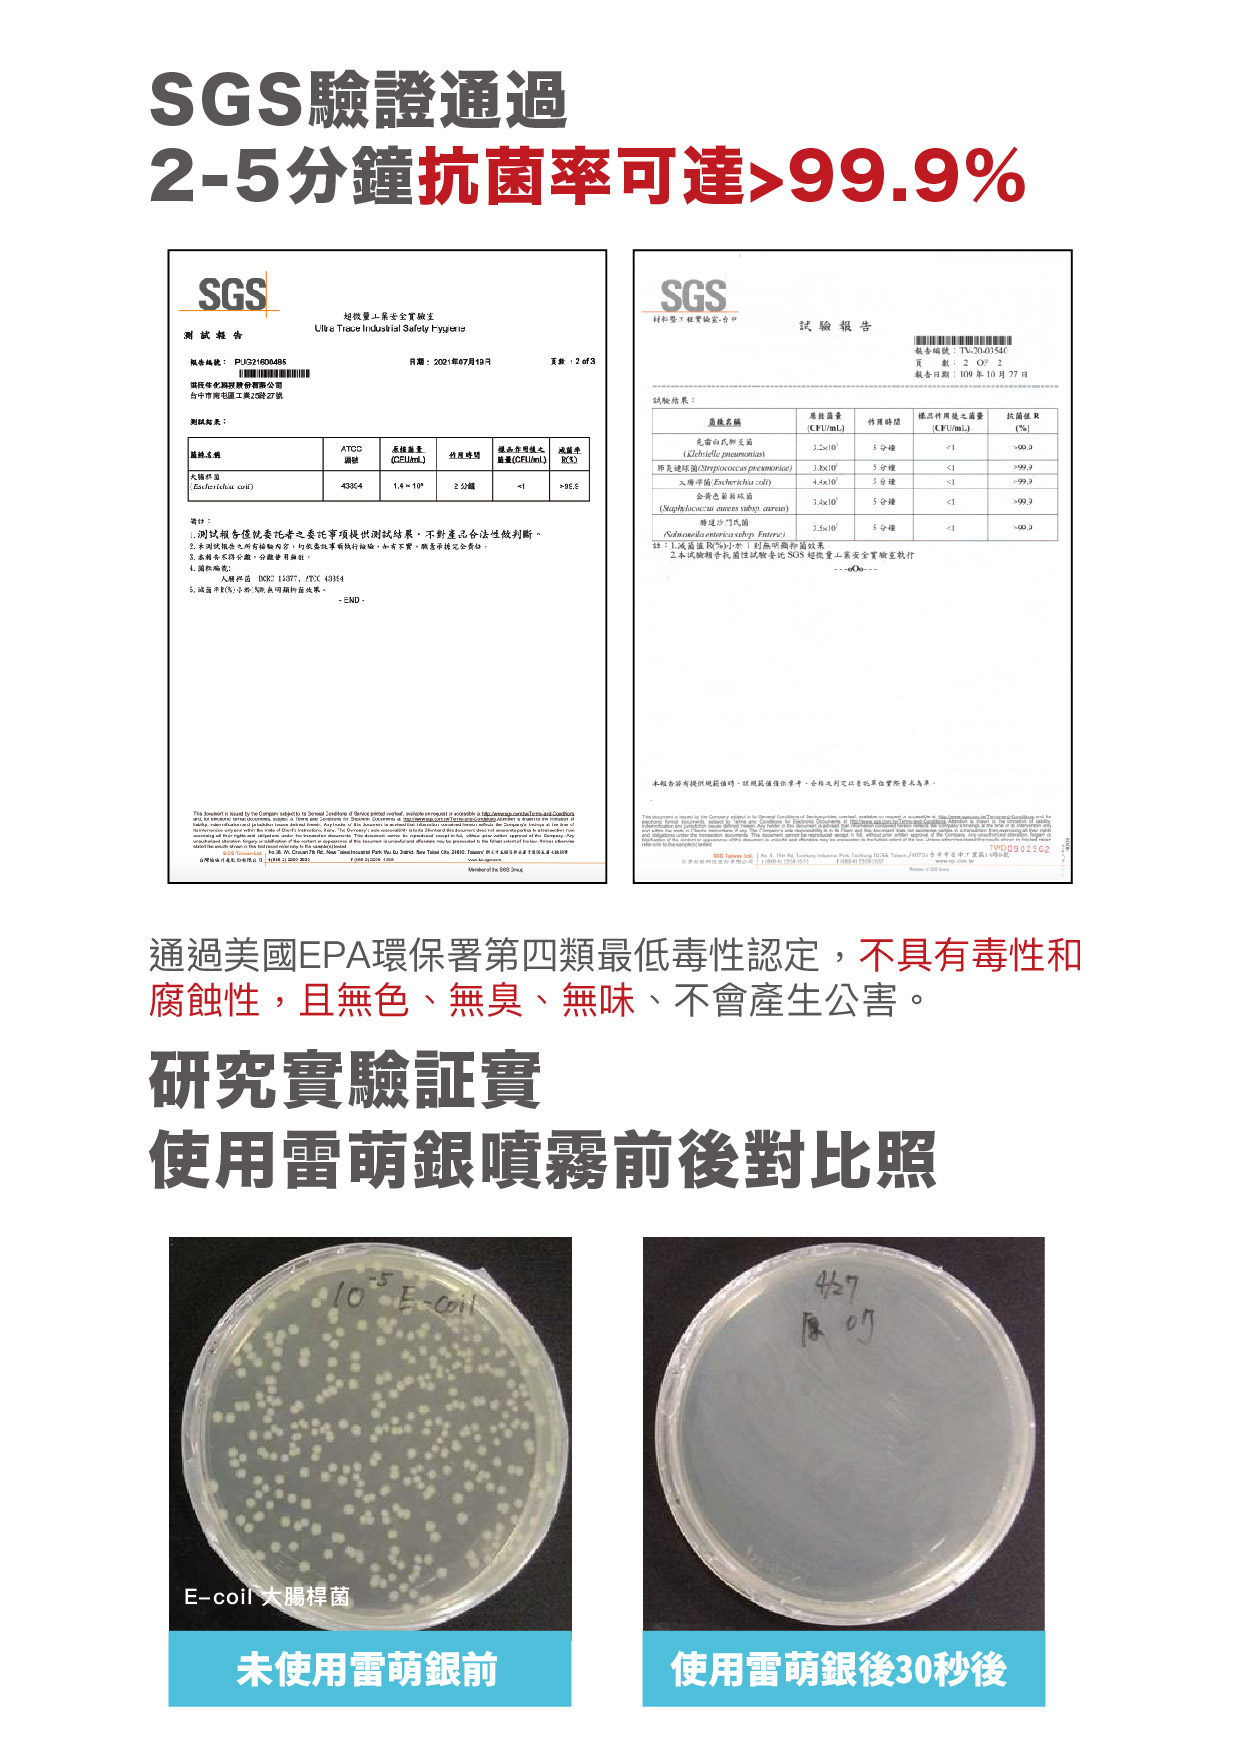

【滿額贈】防護抑菌噴霧 x1 + 防護潔手凝露 x1 <香味隨機>
- Regular price
- NT$ 289.00
- Regular price
-
NT$ 0.00 - Sale price
- NT$ 289.00
分享
*下單時請備註味道
● 雷萌銀防護抑菌噴霧100ml (純淨無味 / 薰衣草花香)
● 雷萌銀防護潔手凝露(純淨無味 / 小蒼蘭)
📌 美國環保署EPA認可SDC制菌成份
📌 溫和不刺激,安全抗菌除臭
📌 不添加酒精 / 無色無味 / 無污染無毒害的抗菌配方
📌 製造日期依瓶身為主;有效期限:未開封5年
📌 如需分裝時,請挑選1號PET、2號HDPE和5號PP塑膠不透光材質,勿使用金屬瓶分裝
注意事項:
1. 本產品含有檸檬酸銀(SDC),因瓶身無法完全隔絕光照,有可能產生黑色沈澱現象,不影響抗菌效果,一樣安全溫和。存放時請放置陰暗處!
2. 請使用不透明罐子進行分裝、且不能照射陽光。
3. 噴霧請不要近距離噴灑,建議使用時微量噴灑即可,如果噴灑量較大、水漬較多(一整片濕、有水痕的情況)、噴灑淺色、白色處,請擦拭乾避免銀離子過多殘留在物品表面上,導致銀氧化的情況!

使用方式
抑制生活空間之病原菌滋生及消除異味。
使用前無需稀釋,以約30公分距離均勻噴灑於需抑菌或除臭之物體表面即 可,無需擦拭。
規格
品 名:紅柿子雷萌銀防護抑菌噴霧 <純淨無味/花香薰衣草>
成 分:SDC (二氫檸檬酸銀)、純水、天然精油
容 量:100ml
有 效 期 限:5年(開封後24個月內使用完畢)
品 名:紅柿子雷萌銀防護潔手凝露 <純淨無味/小蒼蘭>
成 分:SDC (二氫檸檬酸銀)、蘆薈凝膠、純水
容 量:30ml
有 效 期 限:5年(開封後24個月內使用完畢)